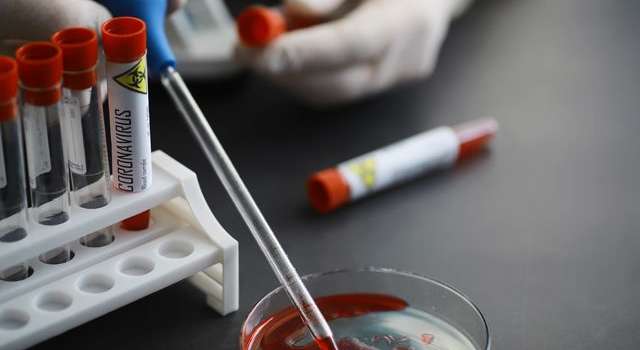

Почти 500 беспилотников, закупленных на средства столицы, отправились на Донбасс в 112 бригаду ТрО Киева, - Кличко. ФОТО
Мэр Киева Виталий Кличко передал почти пол тысячи дронов бойцам 112-й отдельной бригады территориальной обороны Киева, защищающих Донбасс. БПЛА приобретены на средства столичного бюджета. censor.net »